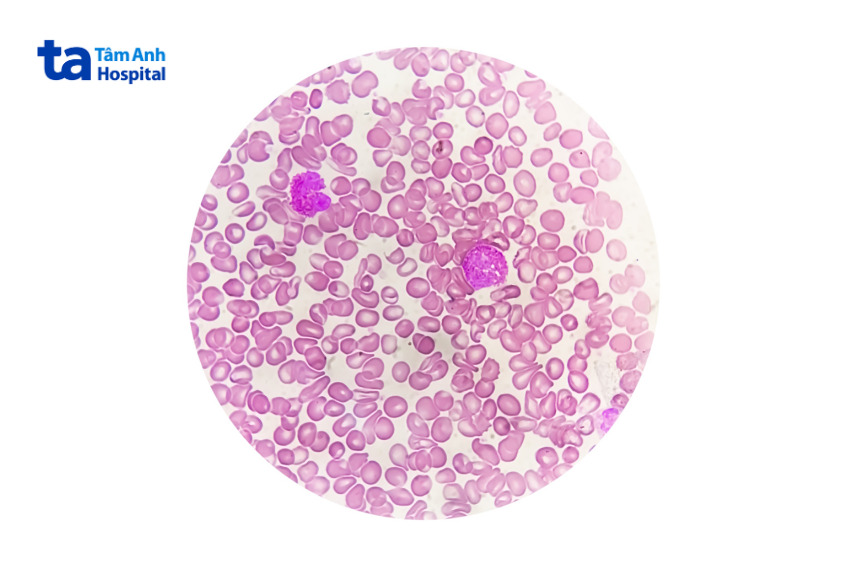
Tế bào hồng huyết cầu bất thường ở người bệnh thalassemia

Các tế bào hồng cầu giúp mang oxy đến các mô và giải phóng carbon dioxide vào phổi để thở ra. Oxy được chuyển thành năng lượng – đây là chức năng thiết yếu giữ cho cơ thể mạnh khỏe. Vậy hồng cầu là gì? Hồng cầu có chức năng gì hay vai trò của chúng là gì?

Hồng cầu (hay hồng huyết cầu) là một loại tế bào máu được tạo ra trong tủy xương và có trong máu. Hồng cầu tiếng Anh là Red blood cells. Những tế bào này chứa hemoglobin – protein giúp vận chuyển oxy từ phổi đến các mô và hỗ trợ chuyển oxy thành năng lượng. Đồng thời, chúng thu nhận carbon dioxide và đưa trở lại phổi để đào thải ra ngoài. (1)
Một số thông tin cơ bản về đặc điểm hình thái và cấu tạo hồng cầu gồm:
Các tế bào hồng cầu có màu đỏ tươi là do hemoglobin – một loại protein cho phép chúng vận chuyển oxy từ phổi, đưa đến các mô khác trong cơ thể. Mỗi tế bào có kích thước rất nhỏ, hình đĩa lõm hai mặt giống bánh rán, dẹt và có lõm ở giữa nhưng không rỗng. Đường kính trung bình của hồng cầu khoảng 6–8 μm.

Tế bào hồng cầu không có nhân như tế bào bạch cầu, điều này cho phép chúng thay đổi hình dạng và di chuyển khắp cơ thể dễ dàng hơn. Một màng kép phospholipid đóng khung cấu trúc của tế bào hồng cầu và được duy trì bởi một mạng lưới các protein tạo nên bộ khung tế bào. Bộ khung tế bào này bao gồm actin, spectrin, protein 4.1, band 3 và ankyrin – cho phép giữ được tính toàn vẹn về mặt cấu trúc tế bào cũng như tính dễ uốn nắn. Sự tương tác giữa những hợp chất này hỗ trợ tạo nên một cấu trúc vững chắc nhưng vẫn mềm dẻo. (2)
Hồng cầu phát triển trong mô xương mềm của cơ thể (tủy xương), giải phóng vào máu khi hoàn toàn trưởng thành. Quá trình sản sinh hồng cầu kéo dài khoảng 7 ngày.
Vòng đời của hồng cầu ở người trung bình sống được trong khoảng 100 – 120 ngày. Chúng phát triển trong tủy xương, trải qua nhiều giai đoạn: từ một tế bào máu, tế bào đa năng trong mô trung mô, trở thành một hồng cầu nguyên bào (normoblast). Trong vòng 2 – 5 ngày phát triển, nó dần dần lấp đầy hemoglobin, nhân và ty thể biến mất. Ở giai đoạn muộn nó được gọi là hồng cầu lưới, sau cùng trở thành hồng cầu trưởng thành hoàn toàn.
Nhìn chung, chức năng hồng cầu bao gồm:
Các tế bào hồng cầu giúp vận chuyển oxy đi từ phổi đến mô trong cơ thể. Các mô tạo ra năng lượng với oxy, thải ra carbon dioxide. Oxy được vận chuyển từ phổi đến các mô ngoại vi để hỗ trợ cho quá trình trao đổi chất, như tổng hợp adenosine triphosphate (ATP).
Hồng cầu còn có vai trò quan trọng trong việc duy trì sự cân bằng kiềm – toan trong cơ thể. Khi thiếu huyết cầu đỏ, khả năng điều tiết kiềm – toan sẽ bị ảnh hưởng, tiềm ẩn nguy cơ gây bệnh (như bệnh về máu).
Độ nhớt của máu được quyết định bởi tế bào máu đỏ và thành phần protein trong huyết tương… Khả năng kết dính của hồng cầu là tính liên quan đến độ nhớt của máu. Độ nhớt của máu có giá trị bình thường là 2,3 – 4,1 centipoise ở 37 ℃.
Một số chỉ số có thể được dùng để đánh giá tình trạng của tế bào hồng cầu:

Các bệnh lý, vấn đề sức khỏe liên quan đến hồng cầu có thể bao gồm:
Ở người bị thiếu máu, máu mang ít oxy hơn bình thường, khiến cơ thể mệt mỏi, cảm thấy lạnh, yếu. Thiếu máu do thiếu sắt là loại thiếu máu xảy ra phổ biến. Một số chứng bệnh thiếu máu khác bao gồm: thiếu máu ác tính, thalassemia, thiếu máu bất sản, bất sản hồng cầu nguyên phát…
Người mắc căn bệnh di truyền này có các tế bào huyết cầu đỏ hình giống nửa vầng trăng thay vì hình tròn lõm bình thường, có thể khiến các tế bào dính, không chảy thông suốt qua các mạch máu, gây tắc nghẽn lưu lượng máu. Điều này có thể gây ra cơn đau cấp tính hoặc mạn tính; dẫn đến nhiễm trùng hoặc làm tổn thương cơ quan. Những biến thể hình liềm này chết nhanh hơn nhiều so với các tế bào hồng cầu bình thường (chỉ sống khoảng 10 – 20 ngày), gây ra tình trạng thiếu hụt tế bào hồng huyết cầu. (3)

Đa hồng cầu đặc trưng bởi tình trạng dư thừa huyết cầu. Trong bệnh đa hồng cầu nguyên phát, số lượng huyết cầu gia tăng do bất thường ở tủy xương. Số lượng hồng cầu cao khiến máu đặc lại, dẫn đến tình trạng đau tim hoặc gây đột quỵ.
Tình trạng hồng cầu thấp thường do bệnh thiếu máu gây ra. Đây là tình trạng có quá ít tế bào hồng huyết cầu để mang oxy đi khắp cơ thể. Những đứa trẻ không có đủ tế bào hồng cầu mạnh khỏe thường tăng trưởng, phát triển chậm hơn trẻ khỏe mạnh. Huyết cầu thấp còn có thể do các bệnh lý như: ung thư máu, suy dinh dưỡng, suy tủy xương, bệnh tuyến giáp…
Số lượng tế bào hồng cầu cao có thể là do lượng oxy bị hạn chế hoặc bệnh lý làm tăng sự sản xuất hồng cầu. Mặc dù ít gặp nhưng tình trạng này xảy ra có thể do một số bệnh lý, ví dụ như: suy tim, đa hồng cầu, dị tật tim bẩm sinh, mất nước do tiêu chảy nặng, bệnh phổi (như COPD, khí phế thủng, xơ phổi), bệnh thận (u thận)…
Vỡ hồng cầu (huyết tan) là hiện tượng tế bào chứa hemoglobin bị phá vỡ, giải phóng hemoglobin cùng những thành phần nội bào vào huyết tương. Việc giải phóng hemoglobin làm huyết tương hoặc huyết thanh có màu đỏ nhạt đến màu đỏ anh đào. Vỡ hồng cầu là kết quả của những cơ chế miễn dịch, sinh lý, sinh hóa hoặc hóa học, có thể là huyết tan nội mạch và huyết tan ngoại mạch.
Đây là tình trạng các tế bào hồng cầu xuất hiện trong nước tiểu, còn gọi là chứng tiểu ra máu. Có thể phân loại tình trạng này thành hai dạng chính, bao gồm tiểu ra máu vi thể và tiểu ra máu đại thể, dựa trên cách xác định mức hồng cầu có trong nước tiểu.
Một số vấn đề sức khỏe có liên quan đến hồng cầu lưới có thể bao gồm: thiếu máu (thường tăng sản xuất tế bào máu đỏ non ở chứng thiếu máu do tan huyết, hồng cầu lưới giảm hoặc không tăng đáng kể ở chứng thiếu máu do thiếu sắt…); các bệnh liên quan (mức hồng cầu non giảm thấp có thể là dấu hiệu của bệnh tủy xương như suy tủy hoặc bệnh bạch cầu, hồng cầu lưới tăng cao có thể gặp ở bệnh tan huyết…); suy dinh dưỡng (thiếu hụt sắt, vitamin B12…) dẫn đến làm giảm sự sản xuất hồng cầu lưới.
Mỗi người có thể tham khảo một số hình ảnh hồng cầu dưới đây:

Một số câu hỏi thường gặp liên quan đến hồng huyết cầu và phần giải đáp:
Ước tính có khoảng 5,2 triệu hồng cầu trên một milimet khối máu ở người trưởng thành. Có khoảng 2,4 ngàn tỷ tế bào huyết cầu đỏ ra đời tính theo từng giây ở người trưởng thành. Gần nửa thể tích máu (40 – 45%) là huyết cầu. Số lượng hồng cầu bình thường khác nhau ở từng người, phạm vi chung bao gồm:
Chức năng của hồng cầu bao gồm: vận chuyển oxy từ phổi đến các mô của cơ thể, vận chuyển chất thải carbon dioxide đến phổi để thở ra, vận chuyển chất dinh dưỡng, cân bằng kiềm, tạo độ nhớt cho máu…
Tình trạng tăng hoặc giảm hồng cầu trong máu có thể nguy hiểm tùy thuộc vào mức độ và nguyên nhân. Nếu sự thay đổi lớn, hoặc do các bệnh lý nghiêm trọng gây ra, tình trạng này có thể ảnh hưởng đáng kể đến sức khỏe.
Để góp phần tăng cường số lượng hồng cầu, mỗi người có thể áp dụng các cách như:

Hồng cầu không thể tự tái tạo hay phân chia. Khi kết thúc đời sống hồng cầu (trung bình 100–120 ngày), các tế bào già sẽ bị thực bào tại gan, lách và tủy xương. Cơ thể sau đó sẽ tái sử dụng sắt và protein từ quá trình này để sản sinh lớp hồng cầu mới thay thế.
Bệnh ung thư máu thường đi kèm với sự giảm sút, triệt tiêu lớn số lượng tế bào hồng cầu. Người bệnh ung thư máu có tỷ lệ tử vong cao nếu không được chữa trị sớm.
Để đặt lịch thăm khám, điều trị bệnh tại Hệ thống Bệnh viện Đa khoa Tâm Anh, Quý khách vui lòng liên hệ:
HỆ THỐNG BỆNH VIỆN ĐA KHOA TÂM ANH
Tóm lại, vai trò của hồng cầu quan trọng với cơ thể, chúng liên tục di chuyển khắp cơ thể để mang oxy đến các mô, giải phóng carbon dioxide khi thở ra… Mỗi người cần chủ động bảo vệ, giữ cho tế bào này khỏe mạnh, góp phần giảm nguy cơ mắc phải những tình trạng rối loạn hồng cầu, đồng thời nên thăm khám, theo dõi sức khỏe định kỳ tại BVĐK Tâm Anh để được tư vấn và quản lý kịp thời.